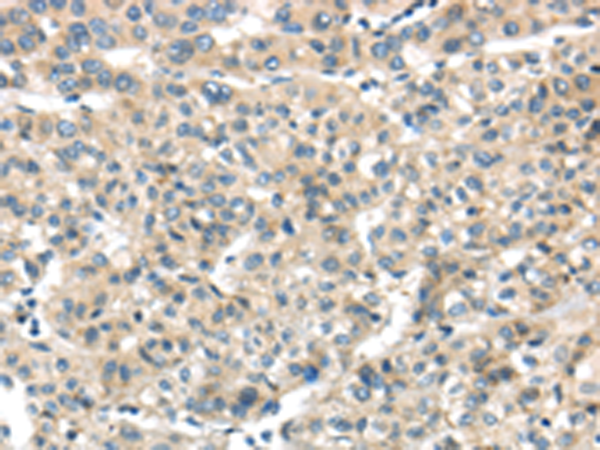
一抗

|
Background: |
THAP2, also named as THAP domain-containing protein 2, is a 228 amino acid protein, which contains one THAP-type zinc finger. Members of the THAP (thanatos-associated protein) family of proteins contain a well conserved DNA-binding domain known as the THAP-type zinc finger motif. Proteins containing the THAP-type zinc finger motif are commonly involved in transcriptional regulation, cell-cycle control, apoptosis and chromatin modification |
|
Applications: |
ELISA, IHC |
|
Name of antibody: |
THAP2 |
|
Immunogen: |
Full length fusion protein |
|
Full name: |
THAP domain containing, apoptosis associated protein 2 |
|
SwissProt: |
Q9H0W7 |
|
ELISA Recommended dilution: |
2000-5000 |
|
IHC positive control: |
Human liver cancer and human thyroid cancer |
|
IHC Recommend dilution: |
25-100 |

 購物車
購物車 幫助
幫助
 021-54845833/15800441009
021-54845833/15800441009